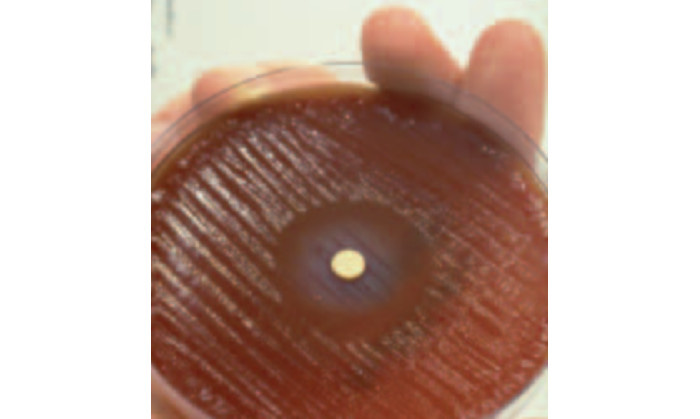

Take Medicine, then
“Physician Heal Thyself”
What is Good Medicine? In a recent post, I made it a lot easier to work this out. We now know what it is not.
We’ve already found that ‘health care’ is an oxymoron, something that’s pretty much out of scope for doctors and other ‘health care’ professionals. The main way clinicians can really contribute to ‘good health’ is by explaining to those in power why we cannot magically confer it. Health is something that stems from healthy communities, built well so as to grow healthy people. Politicians can make health happen, but especially now, most of them seem to focus on converting short-term profit-taking into very poor community health.1 Doctors just can’t make you healthy. And politicians almost universally work in short election cycles, which clouds their future vision. On a clear day, many can almost see past the tips of their lying noses.
So where does this leave us clinicians? The best clinicians naturally do community medicine, and epidemiology: people who can still make a health difference within the rather narrow confines of what we call ‘Medicine’. As far as they are permitted by the above politicians. They constitute a small and often neglected part of the medical workforce. The rest of us are left to do what doctors, nurses, and allied health professionals do best: mitigate misery, manage long-term conditions, and achieve occasional cures. We can also confer potent protection with vaccines, of course.
This may sound as if I’m diminishing our role to almost nothing, but as we shall discover in forthcoming posts, like politicians, poverty and people punting Jesus, disease is always with us, and always will be. Now that we’ve identified what our proper job is—the proud ambulance at the foot of the cliff—perhaps we can find out how to do it well. Let’s not pretend that we as clinicians can prevent all of those non-communicable diseases that will eventually kill most of us. Instead, let’s do our real work: mitigation and palliation. Let’s do it even better, and ever better. But how?
What is Good Medicine, then?
You know what Good Medicine is. Everyone does. It’s what you want. It’s having all of your ‘medical problems’ managed the best they can be managed. Without fear or favour. What every thinking person wants.
There are all sorts of problems clinicians can address. We can help to manage mental and emotional problems; physical problems; and the interface between the two. Problems that are already there, and problems that are all-too-predictably about to happen.
With a blood sugar of 12 mmol per litre (/L), a blood pressure of 160/100, a total cholesterol of 8 mmol/L, drinking several beers a day & smoking like a chimney, someone may still feel healthy. For now. No stroke, no heart attack, no cancer, no kidney failure and no eye troubles yet, but these are looming. As a clinician, I can’t erase the problems, but I can often institute some treatment that will lower the risk dramatically. Lifelong treatment. Lifelong mitigation.2 3
The issue with Medicine is that we clinicians often don’t do it that well. We have our successes, but for several reasons they’re inconsistent. The solution is not to reject Medicine or supplant it with something useless (or worse), but to do it better. We’ll explore this idea over several posts. On our journey, we’ll also find that some people get too little Medicine, and some, too much. The Goldilocks zone for Medicine is fairly narrow. There are lots of other troubles, too. Most of these are fixable. But you have to identify the problems. The actual problems. You can then see how hard it is to fix them, optimally.
Why is fixing Medicine so hard?
I can see five main reasons why fixing the ‘fixable’ problems with Medicine is almost intractably difficult. Here they are:
People in power try to fix the wrong ‘problems with Medicine’.
Medicine is a vast, rusty dreadnought with massive inertia. It resists change.
Funding is always inadequate (and as noted, diverted to the wrong problems)
There are always trade-offs. Most of these are horribly difficult to balance up.
Doctors can be a bit prickly.4
We’ll look at these soon. But first, some basic rules.
So how do we fix Medicine?
Over the past several posts, I’ve provided a toolbox that should allow you to work out most of the fixes for yourself. Let’s list what we know.
We understand quite generally how to manage problems. We call this Science. ‘All’ we need do is contextualise this as Medical Science.
We know that we need ground rules, and that these can be tested and built on. These are never certain, but still pretty damn solid, in context. Flout the rules, and you’re usually (a) wrong and (b) part of the problem.
We have also learnt about efficiency, especially efficient design. We understand concepts like a single source of truth, and how to design and build upon this.
We also know a lot of ways not to ‘make Medicine better’. Specifically, we understand Goodhart’s law, and why league tables are a bad thing. We know that ontologies are at best temporary conveniences, and at their worst, poison.
We know how to measure things, and how to spot changes over time, both good and bad.
We understand the importance of Deming’s 14 principles.
We know not to treat people like things. We know how important it is to work together. We understand win-win, and why it is a superior way to do things.
We are also starting to understand bias and error, and how to measure and fix them. We get Bayes, and even know where Jaynes meets Popper.
Now, let’s look at that list.
Is it broken? Where?
A lot of the failures to fix Medicine are committed by people who don’t understand Medicine. They often fail spectacularly, in different ways.
The commonest failure is “Divide and Conquer”. If, for example, people are waiting too long in emergency departments (EDs), a politician ex machina will swoop in and do what politicians do best: misunderstand. They will try to separate out something that seems fixable, and gives good optics.
They will flout Deming’s principles; they will set targets; they will shout at people, and punish those who transgress the targets; and because targets are now being met as predicted by Goodhart, they will boast about this and move on to comprehensively break some other aspect of ‘health care’, quite possibly by trying to address the patients who are now dying in the understaffed Ear, Nose and Throat ward, where they have been moved to meet the ED targets.
The second type of failure is more spectacular. ‘Health’ systems are all joined up, often in the wrong ways. If you push just here, something unexpected will often pop off over there. But why not just throw squillions of your local currency at a huge fix for the entire ‘problem’?
We’ve seen this too. Often, the solution involves information technology (IT), which gotta be good, right? Politicians love this sort of thing. Large companies like Fujitsu (of British Post Office fame), Accenture (formerly part of Arthur Andersen) and IBM (behind the FAA’s Advanced Automation System) also love ambitious projects, because it rakes in billions.
Take the National Program for IT. NPfIT. This was a product of the UK’s NHS Connecting for Health agency, founded in 2005. The strategy was bold—a central “data spine” that linked up the whole of health care in England, including 30,000 general practitioners, to a unified electronic patient record.
The big problem with NPfIT was not that it blew at least £14 billion out of its butt, and delivered nothing. The big problem can best be expressed using a military metaphor I learnt some decades ago. NPfIT looked “like a sack of shit tied up all wrong.” And that was because it was. The authors seem to have had no understanding of what the actual problems were, no strategic vision of how to address these problems, and therefore no clear path to implementation.
What they did have in abundance was desires, and ideas, and the hope that IT would fix, well, something. In future posts, I’ll minutely examine this sort of thinking. History now tells us rather emphatically it doesn’t work, but this won’t stop more people from trying.
The Dreadnought
Space is big. Really big. You just won't believe how vastly, hugely, mind-bogglingly big it is. I mean, you may think it's a long way down the road to the chemist, but that's just peanuts to space. [Douglas Adams, The Hitchhiker’s Guide to the Galaxy]
Medicine is worse than space. it’s bigger on the inside. Medicine is huge and complex. No, that understates the problem. Medicine has accreted over hundreds of years, and is fucking complex. Nope, that still understates the problem.
‘Medicine’ is a complex mess-up of the entirety of human illness, human hopes and fears, human weaknesses and insecurities, defective social structures, political opportunism, shonky supply chains, defective processes; and a stew of anatomy that varies—the manual is often wrong; of physiology that in turn is a complex amalgam of your genes, epigenetic factors, and the rich stew of your environment—the manual is mostly wrong; of pathophysiology that juxtaposes the above and a seemingly endless supply of pathogens and xenobiotics and human-made chemicals, not the least of which are a bewildering array of pharmaceuticals—the manuals of which are not just mostly and unintelligibly wrong but also mostly unwritten. And that’s just getting started. Multiply this by eight billion, add in wars and historic grievances and weird political systems, and a lot more. That’s Medicine in the large.
Medicine has inertia. Medicine is like this vast rusting hulk of an oil tanker, where you haul on the wheel to start a turn—and the rudder responds seventeen years later. Well, that’s if you believe the widely cited report by Balas & Boren in 2000. As you might expect, this number is a bit hand-wavey. Not all research translates into effective deployment, and sometimes really unreliable research is aggressively marketed, rapidly taken up, and turns out to be nonsense.5
But let’s take a practical and familiar example. In my final year at medical school6 my last surgery exam was mostly devoted to one topic—the differences between the various types of surgery for peptic ulcer disease. The dogma here was simple:
Acid causes ulcers. No, really. I assure you. Honest.
“Honest. Trust me, I’m an upper gastrointestinal surgeon, whose bread and butter comes from doing operations on peptic ulcers. When you’re sick of Zantac or Tagamet, I’m the answer. Ignore the fact that even after a part of your stomach had been cut out, the ulcers often came back on the margin of the anastomosis (joined up bit).”
At the same time as I was graduating, two Australians had different ideas. Robin Warren, who died last year at the age of 87, was a pathologist at the University of Western Australia. Barry Marshall was a registrar in Internal Medicine who joined Warren in studying strange, spiral bacteria that were able to thrive in the hydrochloric acid of the stomach, where the pH is often in the range of 1–3. Serendipitously, they discovered that the bug (Helicobacter pylori) grows more slowly than most conventional disease-causing bacteria. They then found a very strong association between ulcers and the presence of the bug, but struggled to publish their findings.
I think we would likely still be chopping out bits of stomachs routinely, but for a spectacular move. Marshall experimented on himself, drinking a rich culture of H. pylori after a baseline look into his stomach, which was plumb normal. To his surprise, within days he developed massive stomach inflammation. Unfortunately “the rest is history”, culminating in a Nobel prize for both of them, is an inadequate summary of what followed.
In his Nobel lecture, from which the picture at the start of this section is taken, Marshall quotes a historian who said “The greatest obstacle to knowledge is not ignorance; it is the illusion of knowledge”. That picture shows how bismuth—even then a popular treatment for ulcers—inhibits the growth of the bug. Marshall however struggled to convince his colleagues. He says:
No amount of logical reasoning could budge what people knew in their hearts to be true.
It took ten years to persuade stomach ‘experts’ that H. pylori is the main cause of the ulcers that afflict one in ten Americans during their lifetime. And that was only because Marshall never gave up, and was a bit of a showman. His self-experiment got into the New York Times. Others gradually came on board.
Tradeoffs
Funding of megaprojects often sucks up funding from smaller ones. Barry Marshall’s experiments cost a few tens of thousands of dollars, and resulted in beneficial changes worth billions. But people like an expensive spectacle. Right until it flops.
Some tradeoffs are subtle and inapparent until you look hard. In a recent (2025) article in the Lancet, Naci and colleagues went through the new drugs accepted by NICE in the UK. NICE is the National Institute for Health7 and Care Excellence. They surveyed 20 years of decisions, and evaluated cost-effectiveness in terms of quality of life (QUALYs are quality-adjusted life-years).
This giant piece of work examined 332 pharmaceuticals, of which 83% were recommended, costing £75 billion. The average (median) gain was half a QUALY in ‘full health’; each such gain cost something in the region of £20,000 to £30,000. The total number of QUALYs generated was about 3.75 million, affecting nearly 20 million people—but if these resources had been spent on improving existing services in the NHS, they would have generated 5 million QUALYs. By their analysis, the new drugs had a net, negative impact on population health.
The effect was particularly pronounced when it came to new cancer drugs, as these are far, far more expensive than (say) new antibiotics. But being seen to “treat cancer” carries more emotional weight with politicians, doesn’t it? It even seems to me that politicians would rather treat cancer expensively than prevent it happening thirty years down the line. The optics are so much better. Likewise with funding huge IT projects that will “fix healthcare”.
In my list of problems, I also noted that “Doctors can be a bit prickly”. This perhaps understates the problem just a tad. There must be a better way of saying this. Ah! Here it is.
Doctors are often full of shit.
There. I said it. I might have phrased this more diplomatically, but as I’m a doctor, I won’t. We’re full of shit. Often. Why is this?
Here’s the thing. I’m certain that in the health care systems where I’ve worked (New Zealand and South Africa) the bulk of clinicians do Medicine because they fundamentally care about people. Sometimes, this is insidiously subverted by profit, but most people still go to work with the intent of doing good. There are a few problems.
One is the problem Marshall noted—that we know in our hearts, things that are true. But they aren’t. Another is that we lack the perspectives, tools and information to improve our local systems. I’ve talked about these tools in past posts, and listed them above. A third issue is that even if we have the tools, we are not given the time and funding to improve things. A fourth is that even if we’re given the time, tools and funding, the juggernaut moves on, and most of us don’t have the determination (and showmanship) to stay the course.8
But there’s a greater problem. Even if we have the information, tools, funding, time, and an environment where everyone around us is supportive and keen to improve things, this issue still looms large.
The patient in front of me
A few months ago, I met a man in clinic. He had a hernia that was bothering him. Some years previously, he’d been offered a surgical fix, but had declined. Now the hernia had become more bothersome, and he’d changed his mind, but circumstances were starting to conspire against him.
I won’t go into the finer details, but he had a bunch of other problems. The biggest was his anaemia (thin blood).9 In fact, six months previously, he’d been found to have a particularly high-risk type of ‘myelodysplastic syndrome’. His expected survival was eight months. That was six months ago. After a lot of discussion, I took the case to our high-risk meeting, where the decision was made to go ahead, based on the consensus of surgeons and anaesthetists. The operation was small and his hospital stay likely to be brief; he was very symptomatic. As it turned out, his condition rapidly deteriorated and he died of untreatable leukaemia just before the surgery was scheduled. Someone else was lucky, and got the operating slot allocated to him; had the timing been slightly different, he would have had a very unfortunate course after his ‘minor’ operation.
We do our best for the individual patient in front of us. We agonise. We discuss problem cases with our colleagues, and come to a consensus. And still we often make suboptimal calls. Some of this is just sheer random variation, but at other times, we’re robbing Peter to pay Paul. That’s because we don’t look widely enough, or think broadly enough. Let’s illustrate this even more clearly.
Let’s say you’re a doctor. A cardiothoracic surgeon. You have very limited resources, and there are queues of people waiting for surgery. You are confronted by two patients. Both need mitral valve replacement surgery. Patient A is young, and otherwise well, apart from their torrential mitral regurgitation. If you operate now, they’ll soon be up and about, and return to a productive life. They have a near-negligible risk of dying from the surgery. Left, they will sicken.
Patient B is a lot sicker. The severity of their leaky valve is just the same as that of Patient A, but they are ‘co-morbid’, and you know that the surgery is more risky. They have a 5% risk of dying from the surgery, and are likely to spend many days in intensive care, and even more time recuperating in hospital. So whom do you operate on first, Patient A, or Patient B?
Pretty much any clinician will want to save Patient B, right? The correct answer is, of course, a problem in queueing theory. The optimal solution is ‘shortest job first’. Then you’ll have time to lavish care on patient B (if they haven’t died already). But many people would see this as a dereliction of duty. The sick person is more ‘deserving’.10
Now multiply this vignette by a thousand. Ten thousand. Local optimisation is often the enemy of system-wide optimisation; and as clinicians, we’re tasked with local optimisation. Our job is often impossible. Is it a surprise that sometimes we’re a bit prickly?11
So how can we do better? Before we start applying some of the tools I’ve listed, I believe we need to delve even deeper into the problems. This will not be nice, especially my next post, which introduces the Palace of Iatrogenesis.
My 2c, Dr Jo.
The image at the start is from NASA.
Or ignoring, sanctioning, or committing genocide in Gaza, and condemning those who survive to a century of bad health, both physical and mental.
Nope, that’s not a contradiction of my original statement about the impotence of clinicians. By the time you’re smoking, boozing, and eating crap food, my ability to get rid of the underlying causes is minuscule. Your government got the health of your community wrong, and fixing it is mostly beyond both your reach and that of your doctors. We ‘cure’ a tiny percentage of alcoholism, and physician-led counselling leads to long-term smoking cessation in just a tiny proportion of people. Dietary modification is mostly a waste of time, because sticking to it is impossibly hard. Some of our drugs work, though. Some even work well. Ask Weighwatchers why they filed for bankruptcy.
If you’re playing the blame game at this point, see my previous post.
Other clinicians, usually less so.
In the early 1980s, yes, I’m a dinosaur.
That word again!
Nobody expects the Spanish Inquisition.
He also had an extremely rare blood group that prevented him accepting most transfused blood. There were only a few potential donors in the whole country. But our transfusion services were up to the task.
There are even scoring systems that perpetuate this sort of thinking. Often they’re wired in.
And yes, some doctors are just shits.

"mitigate misery, manage long-term conditions, and achieve occasional cures. We can also confer potent protection with vaccines, of course."
Ilth management?
I’ve always had a negative feeling about the A.M.A. because they seemed to espouse a lot of old and incorrect medical "beliefs". I think they (and doctors in general) have stronger beliefs in their "beliefs" than the average person because they know they are smarter and more knowledgable than the average person. "Beliefs" could be scientific discoveries that have been or should be discredited.